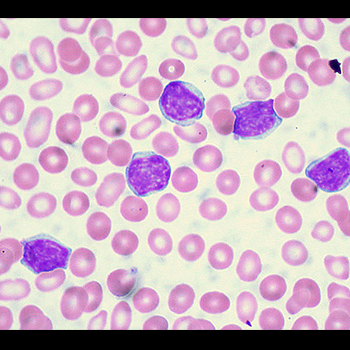

Fragmentos de ADN pueden controlar el crecimiento de tumores
Sady Marcela López Ocampo, magíster en Ingeniería Biomédica de la Universidad Nacional de Colombia (U.N.), se encargó de modelar un señuelo dirigido a tratar tumores de cáncer de mama y próstata. Este fue diseñado por el Grupo de Farmacogenética del Cáncer, del Departamento de Farmacia de la Facultad de Ciencias, junto con la Maestría en Genética de la U.N.
En la imagen: Modelación de la interacción del señuelo de ADN con la con la proteína./ Fotos Sandy López
Se trata de alternativas terapéuticas dirigidas en las que se ha trabajado el desarrollo de fármacos que inhiben blancos específicos dentro de las células cancerosas que conforman el tumor, empleando pequeños fragmentos de ADN de doble cadena, que contienen secuencias con una alta afinidad para atacar a un factor de transcripción específico (proteína).
El señuelo tiene el propósito de bloquear directamente la subunidad alfa de la proteína HIF-1, muy relacionada con procesos tumorales. Los ensayos in vitro realizados por el Grupo de Investigación permitieron establecer que el señuelo favorecía la actividad apoptótica, que se refiere a la muerte celular a la que normalmente se resisten las células cancerígenas.
Sin embargo con el trabajo en laboratorio no era posible determinar la interacción entre el señuelo y la proteína para entender por qué se obtenían esos resultados exitosos, lo que motivó el trabajo de la investigadora López para entender estos procesos a través del modelado computacional en 3D del señuelo y la proteína, y la simulación de la dinámica molecular para ver cómo ambos interactúan a lo largo del tiempo.
El proceso computacional tardó cerca de tres meses continuos en un computador paralelo dedicado (llamado GPU, Graphics Processing Unit). Para ello se contó con las herramientas proporcionadas por el Laboratorio de Investigación en Sistemas Inteligentes (LISI), dirigido por el profesor Luis Fernando Niño, y con la asesoría del investigador posdoctoral Juvenal Yosa, beneficiario de la convocatoria “Es tiempo de volver” de Colciencias. Así, la investigadora pudo identificar que las dos subunidades que conforman el factor de transcripción trabajan como una pinza que atrapa al señuelo.
“En mi tesis hacemos la analogía con las plantas carnívoras, en las que una vez la mosca llega a la venus ella se cierra. Es exactamente lo mismo que pasa con nuestro factor de transcripción, él se cierra y nuestro señuelo queda atrapado”, explica la investigadora López.
La proteína atrapa al señuelo como las plantas carnívoras a las moscas.

Al quedar atrapado, la cadena de ADN real no va a poder entrar en ese espacio que ya está ocupado evitando que se produzcan los factores que ayudan a la célula a vivir en medios de poco oxígeno.
Ese es el objetivo final, debido a que las células tumorales cancerosas son generadas por una desregulación de genes que les permiten adquirir habilidades como proliferación incontrolable, resistencia a la muerte celular, aumento de procesos angiogénicos –formación de vasos sanguíneos nuevos a partir de los vasos preexistentes– y evasión inmune.
El señuelo se trabajó en líneas tumorales de cáncer de mamá y próstata.
Procesos regulados por factores de transcripción, como el que se bloquea con el señuelo, las ayudan a sobrevivir, proliferar, invadir y crecer.
En el estudio también se realizó el modelamiento de tres modificaciones del señuelo para evitar su degradación cuando entra en el cuerpo y mejorar su actividad. Con estas simulaciones se obtuvo que la modificación 2’-flúor del señuelo fue la que presentó la energía de interacción más baja, lo que evidencia una posible mayor resistencia a la degradación y que no afecta la unión del señuelo y la proteína.
Dentro del estudio este fenómeno se nombró como mecanismo venus fly trap

Fuente:
UNAL